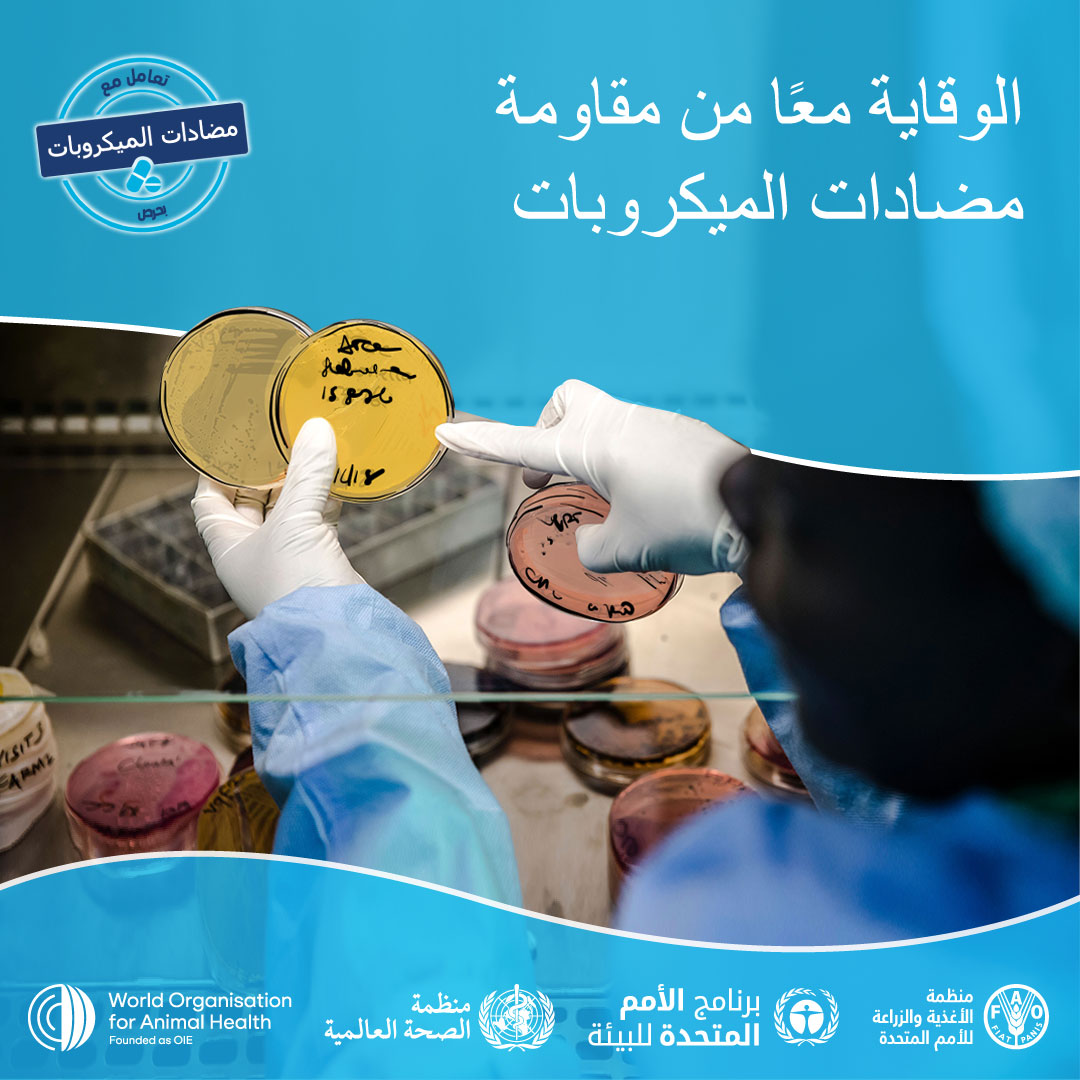
Header

الأسبوع العالمي للتوعية بشأن مضادات الميكروبات (WAAW) هو حملة عالمية لزيادة الوعي والفهم لمقاومة مضادات الميكروبات وتعزيز أفضل الممارسات بين أصحاب المصلحة في صحة واحدة. يتم الاحتفال بـ WAAW كل عام في الفترة من 18 إلى 24 نوفمبر.
موضوع WAAW 2022 هو “الوقاية معاً من مقاومة مضادات الميكروبات“.
ستجد أدناه دليل الحملة الذي تم تصميمه لتزويدك بالمعلومات الأساسية حول كيفية المساهمة في هذا الحدث. نأمل أن يلهمك ذلك لتطوير أنشطتك المحلية. دعمكم بالغ الاهمية لنجاح هذه الحملة!
انقر هنا للحصول على الدليل الكامل